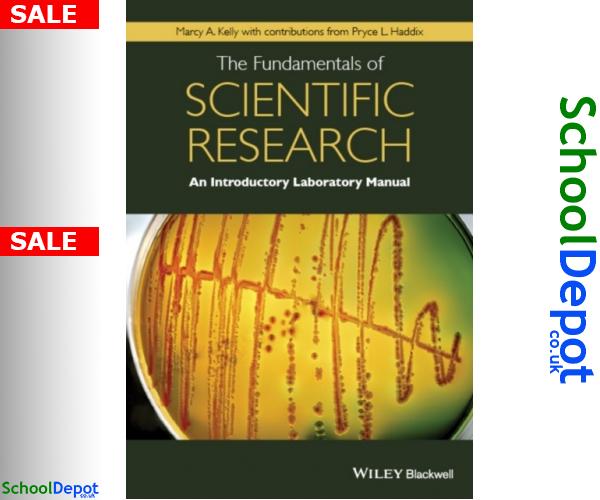

Fundamental science is
Школа фитнеса лучшие
Математический маятник за 40 с совершил 8
А мы стиляги такие бархатные тяги
Новые правила оформления сим карт
Собственный капитал организации составляет
Липучки нокиан хакапелита
Мастика битумная технониколь 31
The heathers песни
Оплата обучения в тинькофф
Газированная вода при пожаре
Давай ты моя жена будешь
Perl pdf
Программа передач на тв евроспорт 2
Fundamental science is 143 фотографий